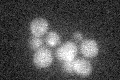
YHR071W
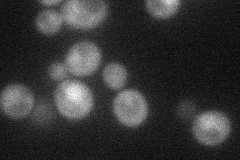
YHR071W
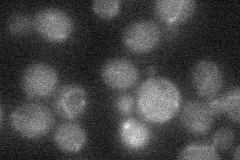
YHR071W
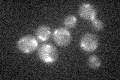
YHR071W

View description
Cyclin, interacts with and phosphorylated by Pho85p cyclin-dependent kinase (Cdk), induced by Gcn4p at level of transcription, specifically required for Gcn4p degradation, may be sensor of cellular protein biosynthetic capacity
Localization:
Intensity:
Fold change:
Significance:
-
C’ GFP library in SD
below threshold17.12 -
N' NOP1pr-GFP in SD
cytosol,nucleus31.9718 -
N' TEF2pr-mCherry in SD

below threshold30.7594 -
N' NATIVEpr-GFP in SD
below threshold20.2956 -
N' TEF2pr-VC and Cyto-VN in SD

below threshold18.1199 -
C’ GFP library in SD+DTT

cytosol17.311.01No -
C’ GFP library in SD+H2O2
cytosol15.60.91No -
C’ GFP library in Starvation Media

cytosol14.870.86No -
C’ GFP library on the background of Pup2-DaMP

N/A -
C’ GFP library on the background of CCT mutant

N/A0N/AYes
